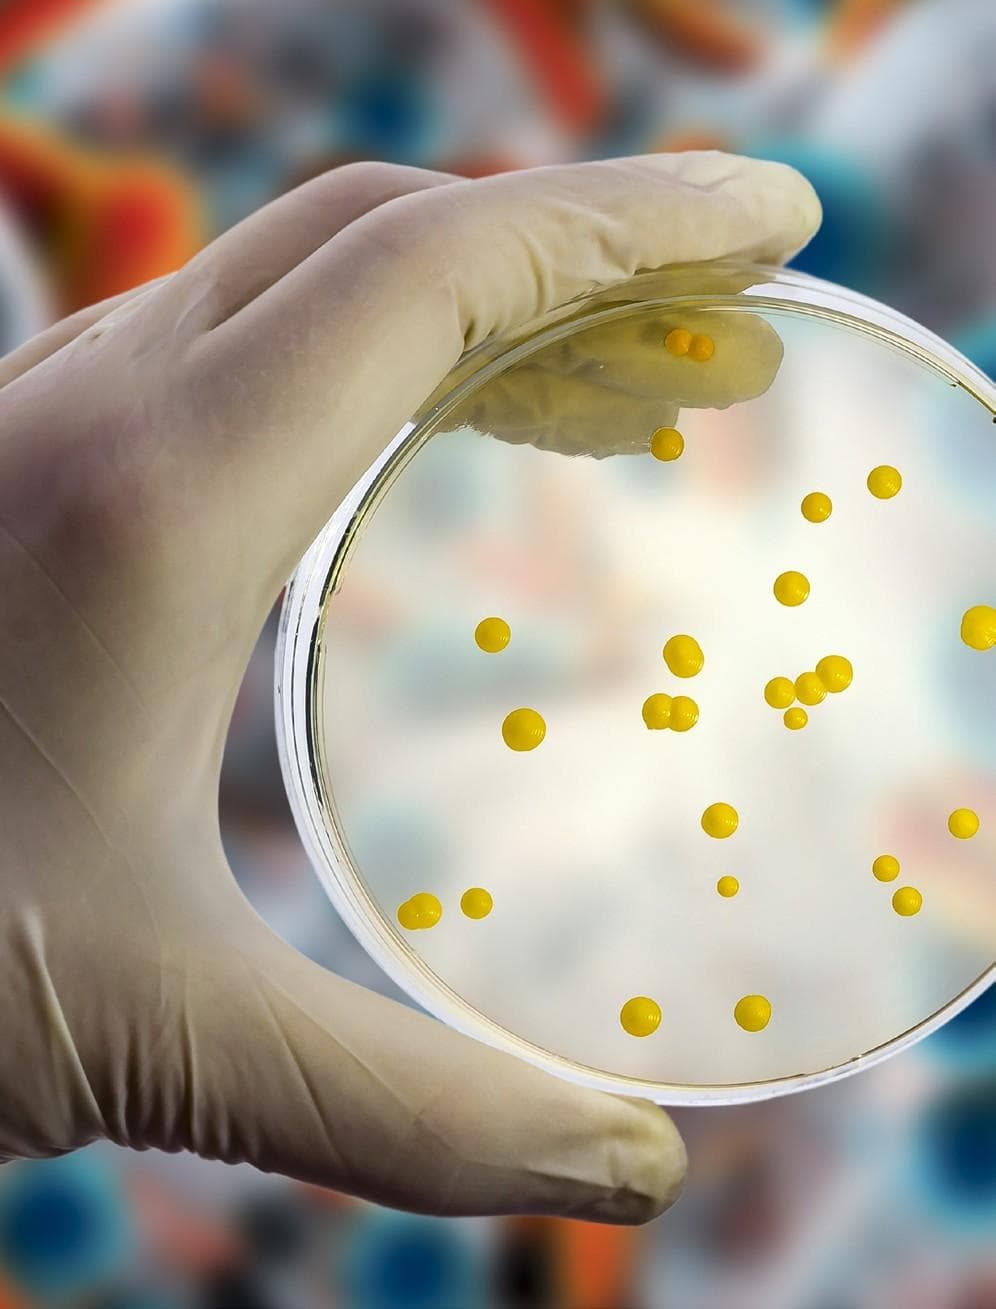
FDA grants IND clearance to Spero Therapeutics’ bacterial infection treatment

44 articles from this collection:

Rezdiffra approved by FDA as first treatment for liver scarring due to fatty liver disease
The FDA has announced that it has approved Rezdiffra (resmetirom) for the treatment of adult patients with noncirrhotic non-alcoholic steatohepatitis (NASH) with moderate-to-advanced liver scarring (fibrosis), for use alongside diet and exercise.

Pharma Times
Www.pharmatimes.com/croy

Gilead and Merck share new data from phase 2 HIV treatment trial
Gilead sciences and Merck (known as MSD outside of the US and Canada) have announced results from the phase 2 clinical study assessing the combination of islatravir and lenacapavir for viral suppression in HIV treatment.

COMMUNIQUE Awards 2024
Communique.awardsplatform.com

Contents
Welcome to the April 2024 issue of Pharmafocus!

Comment
Considering the landscape of women’s health in 2024

PharmaRole
Pharmarole.com

Roche announces new data for continuous glucose monitoring system
Roche has shared the latest data on its novel solution for continuous glucose monitoring (CGM), including a CGM sensor and two apps designed to present current glucose values and predictions over 30 minutes and two hours.

EMA accepts two applications for datopotamab deruxtecan for oncology treatments
AstraZeneca has announced that the European Medicines Agency (EMA) has validated two marketing authorisation applications (MAAs) for AstraZeneca and Daiichi Sankyo’s datopotamab deruxtecan (dato-dxd) in the treatment of two cancers.
FDA grants IND clearance to Spero Therapeutics’ bacterial infection treatment
Spero Therapeutics has announced that it has gained FDA clearance for the investigational new drug (IND) application to assess SPR206 in a phase 2 clinical study.

Amneal and Zambon Biotech to collaborate for Parkinson’s treatment
Amneal Pharmaceuticals has announced that it has entered into an exclusive licensing agreement with Zambon Biotech for IPX204 in the EU, UK and Switzerland.

GSK announces data from phase 3 trial for Jemperli combinations for endometrial cancer
GSK has announced positive results from part 1 and part 2 of its ruby/engot-en6/gog3031/ nsgo phase 3 trial for Jemperli (dostarlimab) in combinations for the treatment of adult patients with primary advanced or recurrent endometrial cancer.

Merck announces data from phase 3 trial for Keytruda in cervical cancer treatment
Merck, known as MSD outside of the US and Canada, has announced positive results from the phase 3 KEYNOTE-a18 trial, which investigates Keytruda in combination with chemoradiotherapy for the treatment of newly diagnosed patients with high-risk locally advanced cervical cancer.

Sanofi announces results from phase 2b for dermatitis treatment
Sanofi has shared positive results from part 2 of the investigational phase 2b STREAM-AD study of Amlitelimab for adult patients with moderate-to-severe atopic dermatitis (ad) who previously responded to Amlitelimab and continued treatment.

Sosei Heptares announces first patient dosed in trial for IBD treatment
Sosei Heptares has announced that it has dosed the first patient in its phase 1 trial assessing a novel ep4 receptor agonist, HTL0033744 (htl’744) for the treatment of inflammatory bowel disease (IBD).

Pharmatimes
Niea.pharmatimes.com

AstraZeneca’s Ultomiris approved by FDA for NMOSD treatment
AstraZeneca has announced that the FDA has approved Ultomiris (ravulizumab-cwvs) as the first and only long-acting c5 complement inhibitor for the treatment of adult patients with anti-aquaporin-4 (aqp4) antibody-positive (ab+) neuromyelitis optica spectrum disorder (nmosd).

J&J’s Opsynvi approved in US for PAH treatment
Johnson & Johnson (J&J) has announced that the FDA has approved Opsynvi (macitentan and tadalafil) for the chronic treatment of adults with pulmonary arterial hypertension (PAH).

Novo Nordisk’s Awiqli recommended by CHMP for diabetes treatment
Novo Nordisk has announced that the European Medicines Agency’s (EMA) Committee for Medicinal Products for Human Use (CHMP) has recommended marketing authorisation for Awiqli (once-daily basal insulin icodec) for the treatment of diabetes in adult patients.

Takeda’s Hyqvia gains MHRA marketing authorisation for CIDP treatment
Takeda has announced that the Medicines and Healthcare Products Regulatory Agency (MHRA) has granted marketing authorisation to Hyqvia as a maintenance therapy for patients of all ages with chronic inflammatory demyelinating polyneuropathy (CIDP) following stabilisation with an intravenous immunoglobin therapy (IVIG).

MEDICAL & SCIENTIFIC EXCELLENCE AWARDS
Msea.pharmatimes.com

J&J MedTech and NVIDIA to collaborate for surgical AI
Johnson & Johnson (J&J) MedTech has announced that it is working in collaboration with NVIDIA to accelerate and scale artificial intelligence (AI) for use in surgeries.

Bayer and Aignostics enter partnership for AI oncology research
Bayer and AIgnostics have announced that they have entered into a strategic collaboration for several artificial intelligence (AI)-powered approaches for precision oncology drug research and development.

SAMEDAN
Www.samedanltd.com

Merck announces plans for HPV vaccines trials
Merck, known as MSD outside of the US and Canada, has announced that it is planning to initiate clinical development of a new investigational multivalent human papillomavirus (HPV) vaccine, as well as assessing a single-dose regimen of Gardasil 9 compared to its approved three-dose regimen.

Allumiqs and Prolytix to collaborate for drug discovery and development
Allumiqs and Prolytix have announced that they have entered into a long-term, strategic partnership with the aim of providing collaborative and integrated solutions for their customers to optimise drug development pipelines.

Innovations in Pharmaceutical Technology
Www.iptonline.com

Fusion Pharmaceuticals to be acquired by AstraZeneca for approximately $2bn
AstraZeneca has announced that it has entered into a definitive agreement to acquire Fusion Pharmaceuticals for an approximate $2bn.

Harpoon Therapeutics acquired by Merck for $650m
Merck, known as MSD outside of the US and Canada, has announced that it has completed the acquisition of Harpoon Therapeutics, meaning it is now a wholly owned subsidiary of Merck.

Ambrx Biopharma acquired by J&J for approximately $2bn
Johnson & Johnson has announced that it has successfully completed its acquisition of Ambrx Biopharma in an all-cash merger transaction with a total equity value of approximately $2bn.

YOURWAY
Www.yourway.com

Compliant connections: making instant messaging work for biopharma field teams
Sebastien Noel from Veeva Systems considers the potential benefits and drawbacks of messaging services for HCPs as well as explaining Veeva’s own platform, which combats these issues

Gen AI and pharma: the future is now
Alex Devereson and Delphine Zurkiya from McKinsey consider the value of generative AI in the pharma industry

Reducing unintended pregnancy rates: how innovation in contraception can drive generational change
Dr Charlotte Owens from Organon explores the impact of innovations in contraception and how this can reduce unintended pregnancy rates

International Women’s Day remains a key platform to keep inspiring inclusive, innovative healthcare
Frances Ramsay from InnoScot Health discusses the way forward in closing the gender health gap

An overview of women’s health in 2024
Betsy Goodfellow from Pharmafocus considers the current landscape of women’s health, covering recent debates and ongoing issues within the reproductive health sphere

FLYPHARMA EUROPE
Www.flypharmaeurope.com

Dr James Malone appointed CTO at BenevolentAI
BenevolentAI has announced that Dr Daniel Neil, current chief technology officer (CTO) is stepping down, to be succeeded by Dr James Malone, who joins the company in April.

Joseph Bertelsen appointed CCO of Nuclera
Nuclera has announced that it has appointed Joseph Bertelsen as chief commercial officer (CCO).

Parexel announces new CEO
Parexel has announced that its CEO, Jamie MacDonald will retire, with the company’s current chief operating and growth officer Peyton Howell taking over as CEO, effective 15 May 2024.

Vynamic appoints new head of life sciences Europe
Vynamic has announced the appointment of Gemma Pfister as head of life sciences Europe.

Five facts about women’s health
Five key facts about women's health

Pharmafocus
Get in touch x.com @pharmafocus

Pharmafile
Www.pharmafile.com
